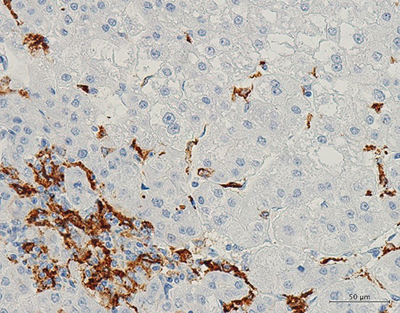
肝臓がん内の腫瘍関連マクロファージM2細胞の図

理化学研究所(理研)生命医科学研究センターがんゲノム研究チームの藤田征志上級研究員、中川英刀チームリーダーらの共同研究グループは、肝臓がんのゲノムデータの詳細な解析により、肝臓がんの局所で起きている複数の免疫抑制機構を発見し、その機構に基づいた肝臓がんの免疫学的分類を行いました。
本研究成果は、肝臓がんに対する免疫療法の開発やその効果を予測するバイオマーカーの開発に貢献すると期待できます。
がんは、ゲノム異常が蓄積することで発症・進行する「ゲノムの病気」ですが、免疫抑制機構を阻害する免疫療法が有効なことから「免疫の病気」ともいえます。
今回、共同研究グループは、これまで理研で解析してきた234例の肝臓がんの全ゲノムでの変異情報と遺伝子発現情報のうち、免疫関連遺伝子に着目しました。コンピュータを用いて、腫瘍内における免疫活動性、抑制状態を計算し、肝臓がんの免疫抑制機構に基づく分子分類を行いました。その結果、CTNNB1[1]群(Wnt・βカテニンシグナル[2]の活性化)、Tregs群(制御性T細胞[3]の発現)、TAM[4]群(腫瘍関連マクロファージM2[4]の発現)、高細胞障害活性(CYT)[5]群(免疫抑制機構なし)の四つの免疫抑制機構が、肝臓がん組織内で活動性があることが判明しました。また、これらの免疫抑制機構は、がん細胞のCTNNB1遺伝子[1]やARID2遺伝子[6]の変異の有無と強く関連していたことから、これらの遺伝子変異が肝臓がんの免疫環境を制御していると考えられます。
本研究は、科学雑誌『EBioMedicine』(3月号)の掲載に先立ち、オンライン版(2月26日付)に掲載されました。
背景
肝臓がんは、日本における部位別がん死亡者数で、男性では4位、女性では6位です。年間約4万人が肝臓がんと診断され、2万7000人以上が死亡しています注1)。さらに、世界全体の部位別がん死亡率では4位で、年間約78万人の肝臓がん患者が死亡しており、特に日本と中国を含む東アジアで発症頻度が高く、世界の死亡者数の7割が東アジアです注2)。
主な原因は、肝炎ウイルスの持続感染であり、世界中の肝臓がんの約75%は、B型肝炎ウイルス(HBV)またはC型肝炎ウイルス(HCV)の感染によるものと推定され、肝炎ウイルスに感染し、慢性肝炎発症から肝硬変を経ると、高い確率で肝臓がんを発症します。
がんは、ゲノム異常が蓄積することによって発症・進行する「ゲノムの病気」です。また、免疫チェックポイント[7]分子であるPD-1[7]を阻害し、免疫抑制機構を阻害する免疫療法がさまざまながんについて有効であることが証明され、「免疫の病気」でもあることも分かってきました。がん細胞にゲノム変異が蓄積すると、新たな抗原(ネオ抗原)が提示され、非自己として免疫細胞からの攻撃にさらされます。がん細胞はこの免疫細胞からの攻撃から逃れるため、さまざまな免疫抑制機能を獲得してきており、がん組織内は一種の免疫抑制状態にあると考えられています。
肝臓がんの免疫チェックポイント阻害剤を用いた臨床試験が国内でも行われていますが、肺がんや悪性黒色腫ほどの高い効果は確認されていません。また、慢性肝炎という肝臓での炎症が基礎にあるため、免疫チェックポイント阻害によって、肝炎・肝機能の悪化や自己免疫疾患[8]の発症などさまざまな副作用の出現が予想されています。そのため、肝臓がん内で起きている免疫反応を把握し、それに応じた免疫療法の開発や治療法を考える必要があります。
共同研究グループは、これまで肝炎ウイルス関連の肝臓がんや混合型肝臓がんの全ゲノムシーケンス解析[9]、RNAシーケンス解析[10]での研究を進め、さまざまなゲノム異常を同定し、ゲノム異常と肝臓がんとの関わりを解明してきています注3、4)。そこで今回は、これらの全ゲノムデータを高度な情報解析技術を駆使して詳細に解析することで、免疫学的な視点から肝臓がんを理解しようと試みました。
- 注1)国立がん研究センターがん対策情報センター「日本のがん最新統計まとめ2018」
- 注2)「WHO IARC Estimated cancer incident, mortality and prevalence worldwide:Globocan 2018」
- 注3)2016年4月12日プレスリリース「肝臓がん300例の全ゲノムを解読」
- 注4)2019年5月21日プレスリリース「肝がんの新しい分化分子分類と診断マーカー」
研究手法と成果
共同研究グループは、これまで理研で取得してきた234例の肝臓がんのゲノム変異データおよび遺伝子発現データのうち、免疫関連遺伝子の発現に着目し、局所の免疫反応に基づく分類を行いました。
まず、T細胞やナチュラルキラー(NK)細胞などが発現しているパーフォリン-1[5](PRF1)遺伝子とグランザイムA[5](GZMA)遺伝子の発現量を組み合わせて、細胞障害活性(CYT)を算出しました。CYTは、がん細胞を攻撃するリンパ球の活性の指標となります。そして、CYT値が高い腫瘍を免疫的に「HOT」、低い腫瘍を「COLD」と分類しました。HOTな肝臓がんを持つ患者は、COLDな肝臓がん患者よりも再発・死亡の割合が低く、予後が良い傾向にありました。一方で、肝臓がん内の炎症と関係なく、慢性炎症が高い活動状態にあるHOTな非がん部の炎症肝臓を持つ肝臓がん患者は、がんの予後が悪く、再発率も高い傾向にありました。このような、肝臓での慢性炎症と肝臓がん組織内の炎症反応の意義づけは大きく異なります。
次に、さまざまな免疫関連遺伝子のRNA発現情報を組み合わせて解析した結果、次のような四つの免疫抑制機構が肝臓がん組織内で活動性があることが判明しました(図1)。
- (1)CTNNB1群(Wnt・βカテニンシグナルの活性化)
COLDな肝臓がんで見られ、がん組織内にT細胞が存在しません。また、βカテニン(CTNNB1)遺伝子の変異が多く観察されます。
Wnt・βカテニンシグナルは、その下流分子を通して細胞の分化・増殖に関与しており、免疫抑制機構が活性化されます。 - (2)Treg群(制御性T細胞の発現)
高い炎症活動が見られるHOTな腫瘍で見られ、その高い炎症活動を抑制するためにTreg細胞の高い活動性が見られます。
制御性T細胞(Treg細胞)は、免疫反応の抑制的制御をつかさどるT細胞で、自己免疫疾患やアレルギーなど過剰な免疫反応を抑制するブレーキとして、また免疫の恒常性維持において重要な役割を果たします。本研究では、肝臓がん組織のRNA発現のデータから、Treg細胞特異的に発現する遺伝子のRNA発現データを組みわせて、Treg細胞の局所の状態を推定しました。 - (3)TAM群(腫瘍関連マクロファージM2の発現)
COLDな肝臓がんに見られ、がん組織内にT細胞は少ないです。
腫瘍関連マクロファージ(TAM)は、がん細胞周囲の微小環境を形成する重要な免疫細胞であり、活性化の様式から大別して、M1型とM2型に分けられます。マクロファージM2は、インターロイキン-10(IL-10)、TGF-β、プロスタグランジン E2などの抗炎症性因子の産生やTreg細胞の浸潤を促すことで抗腫瘍免疫を抑制し、種々の血管新生因子を産生し新生血管を誘導することで、がん細胞の増殖に都合の良い微小環境を提供します。 - (4)高CYT群(免疫細胞障害性の活動は高いが、免疫抑制機構なし)
HOTな腫瘍でT細胞の浸潤が見られますが、上記三つの免疫抑制機構は明らかに働いていません。免疫チェックポイント分子の活性が高いことから、免疫チェックポイント阻害剤による治療の効果が期待できるかもしれません。

図1 肝臓がんの四つの免疫抑制機構に基づく分類
細胞融解活性(CYT)およびさまざまな免疫関連遺伝子の発現データより、四つの肝臓がんの免疫的分類(赤色矢印)を行った。CTNNB1群では、Wintβカテニンシグナルの活性化が、Tregs群ではTreg細胞の発現が、TAM群ではマクロファージM2の発現が見られ、CYT群では免疫抑制機構がない。
全ゲノムシークエンス解析の結果、肝臓がんでは、さまざまな遺伝子の変異が検出されていますが、それらの免疫抑制機構は、がん細胞のCTNNB1遺伝子とARID2遺伝子の変異と強く関連していました。ARID2遺伝子の変異のある肝臓がんでは、腫瘍関連マクロファージM2がより多く観察され(図2)、肝臓がんの免疫抑制が引き起こされていると考えられます。
また、肝臓がん細胞株にARID2遺伝子の変異を導入すると、複数のケモカイン[11]やサイトカイン[12]の発現量が増減することが分かりました。肝臓がん細胞は、ゲノムDNAのクロマチン[13]構造を制御するARID2タンパク質によって、ケモカインやサイトカインの発現を制御しています。それによりがん細胞の免疫微小環境を誘導しており、がん組織で局所的な免疫抑制状態になると考えられます。
図2 肝臓がん内の腫瘍関連マクロファージM2細胞
免疫組織染色法により、肝臓がん細胞の間に腫瘍関連マクロファージM2細胞(褐色)を検出した。
今後の期待
本研究により、肝臓がんにおける免疫抑制機構の詳細が解明され、これら免疫抑制機構に基づく肝臓がんの分類が可能となりました。それぞれの免疫抑制機構を標的とした肝臓がんの免疫療法の開発戦略が考えられ、また、その免疫分類に応じた免疫治療の層別化が期待できます。特に、免疫抑制機構が働いておらず、免疫学的にHOTなCYT群の肝臓がんは、免疫チェックポイント阻害治療の効果が期待できるかもしれません。
補足説明
- 1.CTNNB1、CTNNB1遺伝子
CTNNB1遺伝子は、Wnt・βカテニンシグナルの中心的分子であるβカテニン(CTNNB1)をコードする遺伝子。βカテニンは核に移行して、下流の遺伝子の転写を活性化する。肝臓がんでは、約30%にCTNNB1遺伝子の変異が観察される。 - 2.Wnt・βカテニンシグナル
Wntとは分泌性の糖タンパク質。Wntにより、β-カテニンが核の中に移動して遺伝子の転写を活性化する。 - 3.制御性T細胞
炎症やアレルギーの発端となる過度の免疫応答を抑制するT細胞亜集団。Foxp3というマスター転写因子を発現する。一般にT細胞は免疫系の司令塔として免疫活性化に働くが、制御性T細胞は他のT細胞の働きを抑制性に制御することにより(この働きが制御性T細胞の名前の由来である)、過剰なT細胞の働きを抑えることで、炎症の収束や自己免疫疾患発症の抑制に重要な役割を果たしている。 - 4.TAM、腫瘍関連マクロファージM2
腫瘍関連マクロファージ(TAM)は、がん細胞周囲の微小環境を形成する重要な免疫細胞であり、活性化の様式から大別して、M1型とM2型に分けられる。マクロファージM2は、インターロイキン-10(IL-10)、TGF-β、プロスタグランジン E2などの抗炎症性因子の産生やTreg細胞の浸潤を促すことで抗腫瘍免疫を抑制し、種々の血管新生因子を産生し新生血管を誘導する。これにより、がん細胞の増殖に都合の良い微小環境を提供する。TAMはTumor-associated macrophageの略。 - 5.パーフォリン-1、グランザイムA、細胞障害活性(CYT)
パーフォリン-1、グランザイムAは、細胞障害性Tリンパ球およびナチュラルキラー(NK)細胞の内部に顆粒状に保存され、リンパ球が活性化すると放出され、がん細胞などの標的細胞の膜に小穴をあけて殺傷する。CYTは、この二つの分子のRNA発現量から計算され、がん細胞を攻撃するリンパ球の活性の指標となる。CYTはCytolytic activityの略。 - 6.ARID2遺伝子
クロマチン構造の形成に重要な役割をしているSWI/SNF複合体は、ARID2やARID1Aなど~10個のタンパク質から構成されている。ARID2遺伝子は、ARID2タンパク質をコードしており、肝臓がんでは約20%のサンプルで不活型の変異が観察される。 - 7.免疫チェックポイント、PD-1
免疫システムには、免疫応答を活性化するアクセルと、抑制するブレーキが存在し、ブレーキ機構は、免疫チェックポイントとして機能し、自己の細胞への不適切な免疫応答や過剰な炎症反応を抑制する。PD-1は、免疫チェックポイントを担う分子の一つで、PD-1の効果を抑制する抗体が、がん免疫療法の最も一般的な薬剤と使われている。 - 8.自己免疫疾患
本来、ウイルスや細菌など外来性異物を排除するために働く免疫システムが、さまざまな要因によって、自己を構成する成分に対しても攻撃(自己免疫反応)して発症する疾患の総称。関節リウマチ、甲状腺の機能異常を引き起こすバセドウ病、1型糖尿病などがある。 - 9.全ゲノムシーケンス解析
次世代シーケンサーを使って、約30億塩基からなる個人の正常細胞やがん細胞の全ゲノム情報を解読し、配列の違いや変化を同定すること。データが大量になるため、スーパーコンピュータを使って情報解析を行うのが一般的である。全ゲノムシーケンス解析の場合、タンパク質をコードする1~2%の範囲のエクソンだけでなく、遺伝子の発現を制御するゲノム領域の変異やさまざまな構造異常(大きなゲノム配列異常)も検出可能で、究極のゲノム解析手法といえる。がんの場合は、がんのDNAと同一患者由来の正常DNAの全ゲノムシーケンス解析を行い、その差分を調べる。 - 10.RNAシーケンス解析
RNAから逆転写したcDNA(RNAと相補的なDNA)を、次世代シーケンサーで全て解析する実験手法。RNAの定量のみならず、新しい転写産物の検出や、スプライシングイベントの定量なども可能である。 - 11.ケモカイン
Gタンパク質共役受容体を介してその作用を発現する塩基性タンパク質。白血球などの遊走を引き起こし、炎症の形成に関与する。 - 12.サイトカイン
細胞同士の情報伝達に関わるさまざまな生理活性を持つタンパク質の総称。 - 13.クロマチン
ゲノムDNAがヒストンタンパク質を代表としたタンパク質に巻き付くことで形成するDNA・タンパク質複合体。クロマチン構造によって、周辺の遺伝子の発現が制御される。
共同研究グループ
理化学研究所生命医科学研究センター
がんゲノム研究チーム
上級研究員 藤田 征志(ふじた まさし)
チームリーダー 中川 英刀(なかがわ ひでわき)
東京大学
医科学研究所
ヘルスインテリジェンスセンター
教授 井元 清哉(いもと せいや)
ヒトゲノム解析センター
助教授(研究当時) 山口 類(やまぐち るい)
教授 宮野 悟(みやの さとる)
医学部附属病院 免疫細胞治療学
特任教授 垣見 和宏(かきみ かずひろ)
東京医科歯科大学 大学院医歯学総合研究所 分子腫瘍医学分野
助教 島田 周(しまだ しゅう)
教授 田中 真二(たなか しんじ)
広島大学
大学院医歯薬保健学研究院 応用生命科学部門 消化器・代謝内科学
教授 茶山 一彰(ちゃやま かずあき)
大学病院 病理診断科
教授 有廣 光司(ありひろ こうじ)
和歌山県立医科大学 第2外科
教授 山上 裕機(やまうえ ひろき)
研究支援
本研究は、日本医療研究開発機構(AMED)次世代がん医療創生研究事業「網羅的免疫ゲノム解析によるがんのゲノム不均一性と免疫環境の理解(領域代表者:中川英刀)」による支援を受けて行われました。
原論文情報
- Masashi Fujita, Rui Yamaguchi, Takanori Hasegawa, Shu Shimada, Koji Arihiro, Shuto Hayashi, Kazuhiro Maejima, Kaoru Nakano, Akihiro Fujimoto, Atsushi Ono, Hiroshi Aikata, Masaki Ueno, Shinya Hayami, Hiroko Tanaka, Satoru Miyano, Hiroki Yamaue, Kazuaki Chayama, Kazuhiro Kakimi, Shinji Tanaka, Seiya Imoto, and Hidewaki Nakagawa, "Classification of Primary Liver Cancer with Immunosuppression Mechanisms and Correlation with Genomic Alterations", EBioMedicine, 10.1016/j.ebiom.2020.102659
発表者
理化学研究所
生命医科学研究センター がんゲノム研究チーム
上級研究員 藤田 征志(ふじた まさし)
チームリーダー 中川 英刀(なかがわ ひでわき)
 藤田 征志
藤田 征志
報道担当
理化学研究所 広報室 報道担当
お問い合わせフォーム
